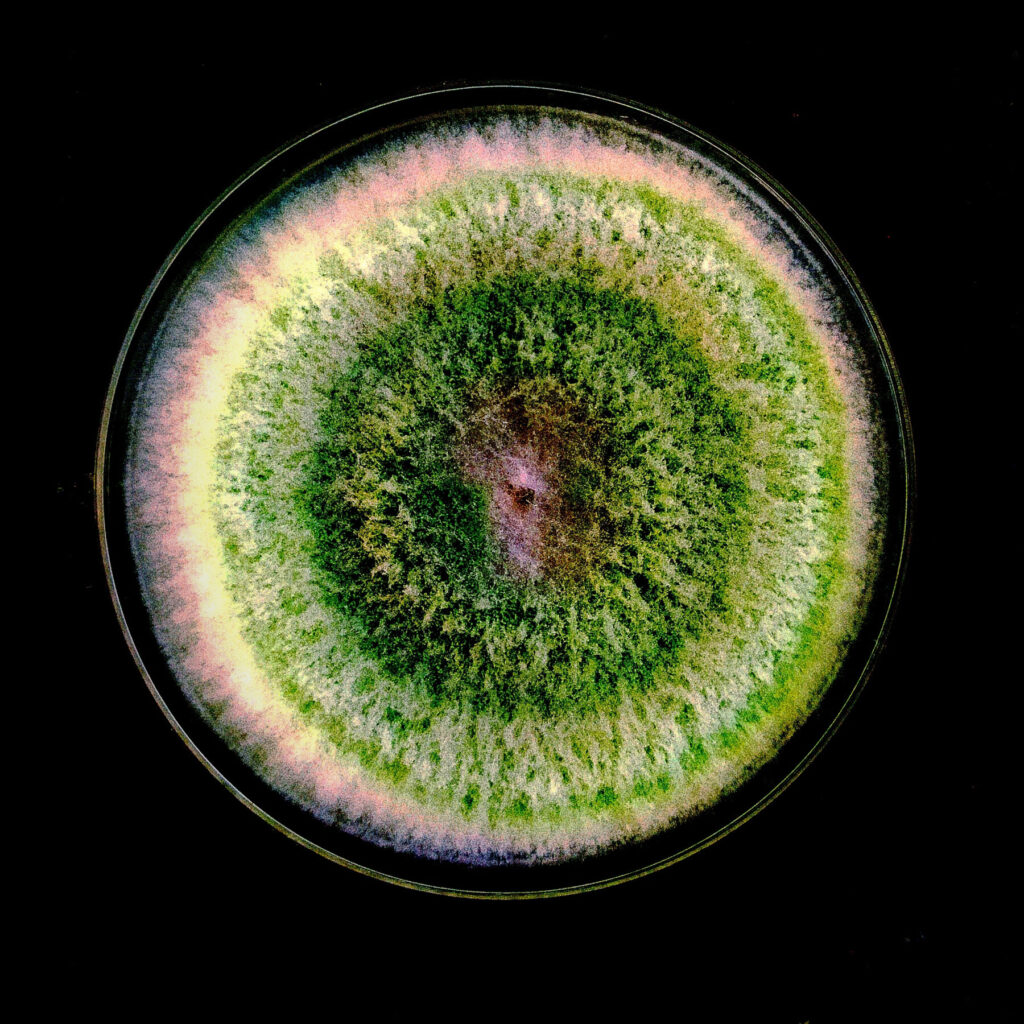

The discovery that sound improves the growth rate of beneficial fungus suggests that dirges in the dirt may help restore forests.The discovery that sound improves the growth rate of beneficial fungus suggests that dirges in the dirt may help restore forests. Read More
Scientists Found a Surprising Way to Make Fungus Happy